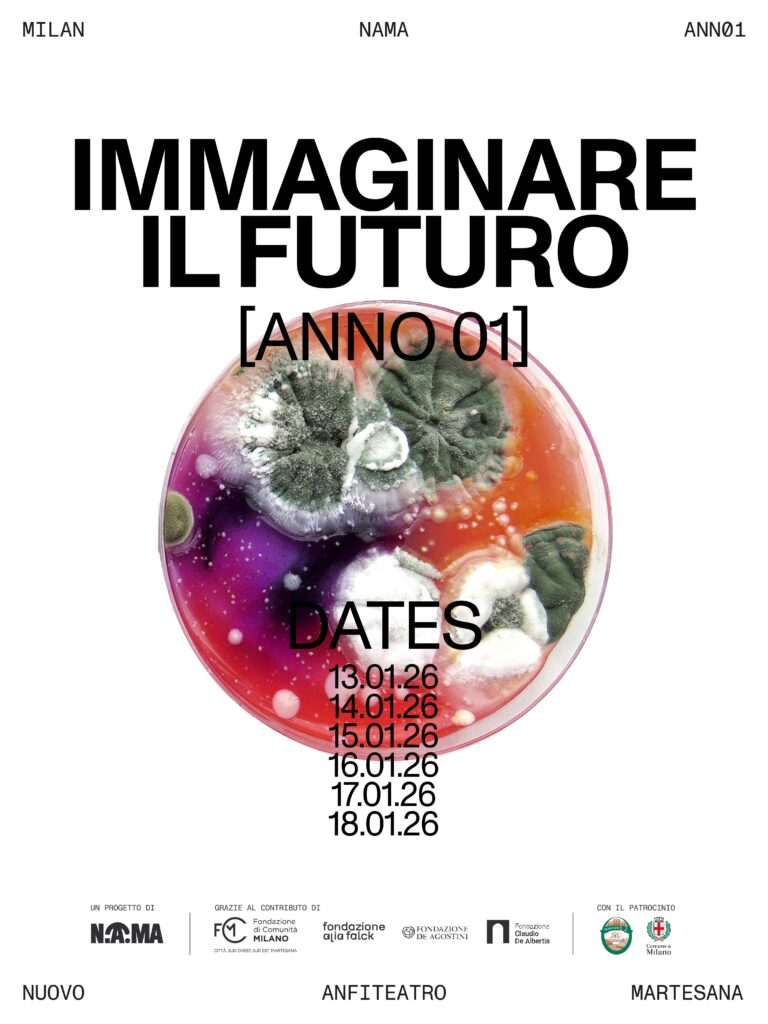

Come NAMA – Nuovo Anfiteatro Martesana, centro culturale giovane e ibrido immerso nel Parco della Martesana – in occasione del nostro primo compleanno – scegliamo di interrogarci su questo:
Lo faremo a partire dal nostro sguardo sul mondo, attraverso il quale scegliamo cosa conta davvero per noi e immaginiamo cosa può cambiare. La cultura, l’arte, il cinema, la musica possono aiutarci a farlo con maggiore consapevolezza, complessità e apertura.
I progressi del digitale e le intelligenze artificiali ci costringono a ragionare di nuovo sulle categorie di reale e irreale, sul futuro dei corpi e sulle modalità di detenzione del potere. I conflitti armati, sempre più vicini a noi, ci hanno risvegliato da un sogno fallace durato molti decenni. Le istituzioni internazionali nate dopo la seconda guerra mondiale con l’obiettivo di essere garanzia di pace e giustizia vacillano. Il difficile superamento del patriarcato, le sue infinite contraddizioni e il rapporto con la violenza di genere interrogano il futuro delle relazioni umane. A causa della crisi climatica, l’umanità si trova nuovamente ad affrontare la possibilità della propria estinzione.
IMMAGINARE IL FUTURO è il festival culturale per il primo compleanno di NAMA: una settimana di incontri, dibattiti, talk, performance, laboratori, eventi musicali e artistici per esplorare insieme il potere dell’immaginazione come strumento di trasformazione personale e collettiva.
Giovanni Abitante, regista
Marco Almagisti, Docente di Scienza politica all’Università di Padova
Bruno Arpaia, scrittore e giornalista
Bianca Bartolomeo, NAMA
Matteo Bevilacqua, creator e co-direttore Ad Astra Dischi
Beatrice Cevasco, NAMA
Andrea Cegna, giornalista e collaboratore di Radio Popolare e Il Manifesto
Francesco Clerici, regista
Ferdinando Cotugno, giornalista
Fabio Deotto, scrittore e giornalista
Bertrand Dezoteux, regista
Martina Di Florio, creator e divulgatrice
Francesco D’Isa, filosofo e divulgatore
Lorenzo Donghi, Università di Pavia
Nicolò Franchi, Coordinatore NAMA
Margherita Fontana, EXT Centro di Ricerca Coordinata sulle Realtà Estese, Università degli Studi di Milano
Pietro Lafiandra, regista
Simone Locatelli, Presidente Municipio 2 del Comune di Milano
Matteo Marelli, Film Tv, Filmmaker Festival
Sergio Marchese, Direttore Artistico NAMA
Clara Mattei, economista, direttrice del Forum per l’Emancipazione Economica Reale presso l’Università di Tulsa, Oklahoma
Margherita Maggioni, sociologa
Giorgio Monoriti, A&R Sugar Music
Luca Mosso, presidente di Filmmaker Festival
Valeria Polidoro, Filmmaker Expanded, Docs Barcelona
Sofia Pasotto, attivista per il clima
Simone Pieranni, giornalista e fondatore di China Files
Flavio Pizzorno, regista
Martina Riva, Assossore alle Politiche Giovanili allo Sport e al Turismo del Comune di Milano
Andrea Rossini, regista
Giulio Sangiorgio, direttore Film Tv
Marco Schiaffino, giornalista Radio Popolare
Paolo Spinicci, ordinario di Filosofia teoretica all’Università degli Studi di Milano
Noura Tafeche, ricercatrice e artista
Noemi Tarantini, giovane content creator con formazione storico-artistica
Nadeesha Uyangoda, scrittrice
Il festival IMMAGINARE IL FUTURO è organizzato in collaborazione con:
Ad Astra Dischi – etichetta indipendente, Anarres – libreria bistrot, Area Zelig – cabaret Milano, Chullu Agency – agenzia di produzione e booking, Conservami – attrezzeria milano, Crea Productions – associazione culturale, Film Tv – rivista di cinema, Filmmaker – festival cinema indipendente, Giardino Nascosto – progetto di NAMA, IO Multimedia – collettivo, Migarden – associazione di promozione sociale, Nenet – associazione culturale, Nolo Runners – running community di Nolo, Ribes Jam – improvvisazioni musicali, Rockers Arena – collettivo, Rockers Arena – collettivo, Spazio Margine – progetto artistico di NAMA

